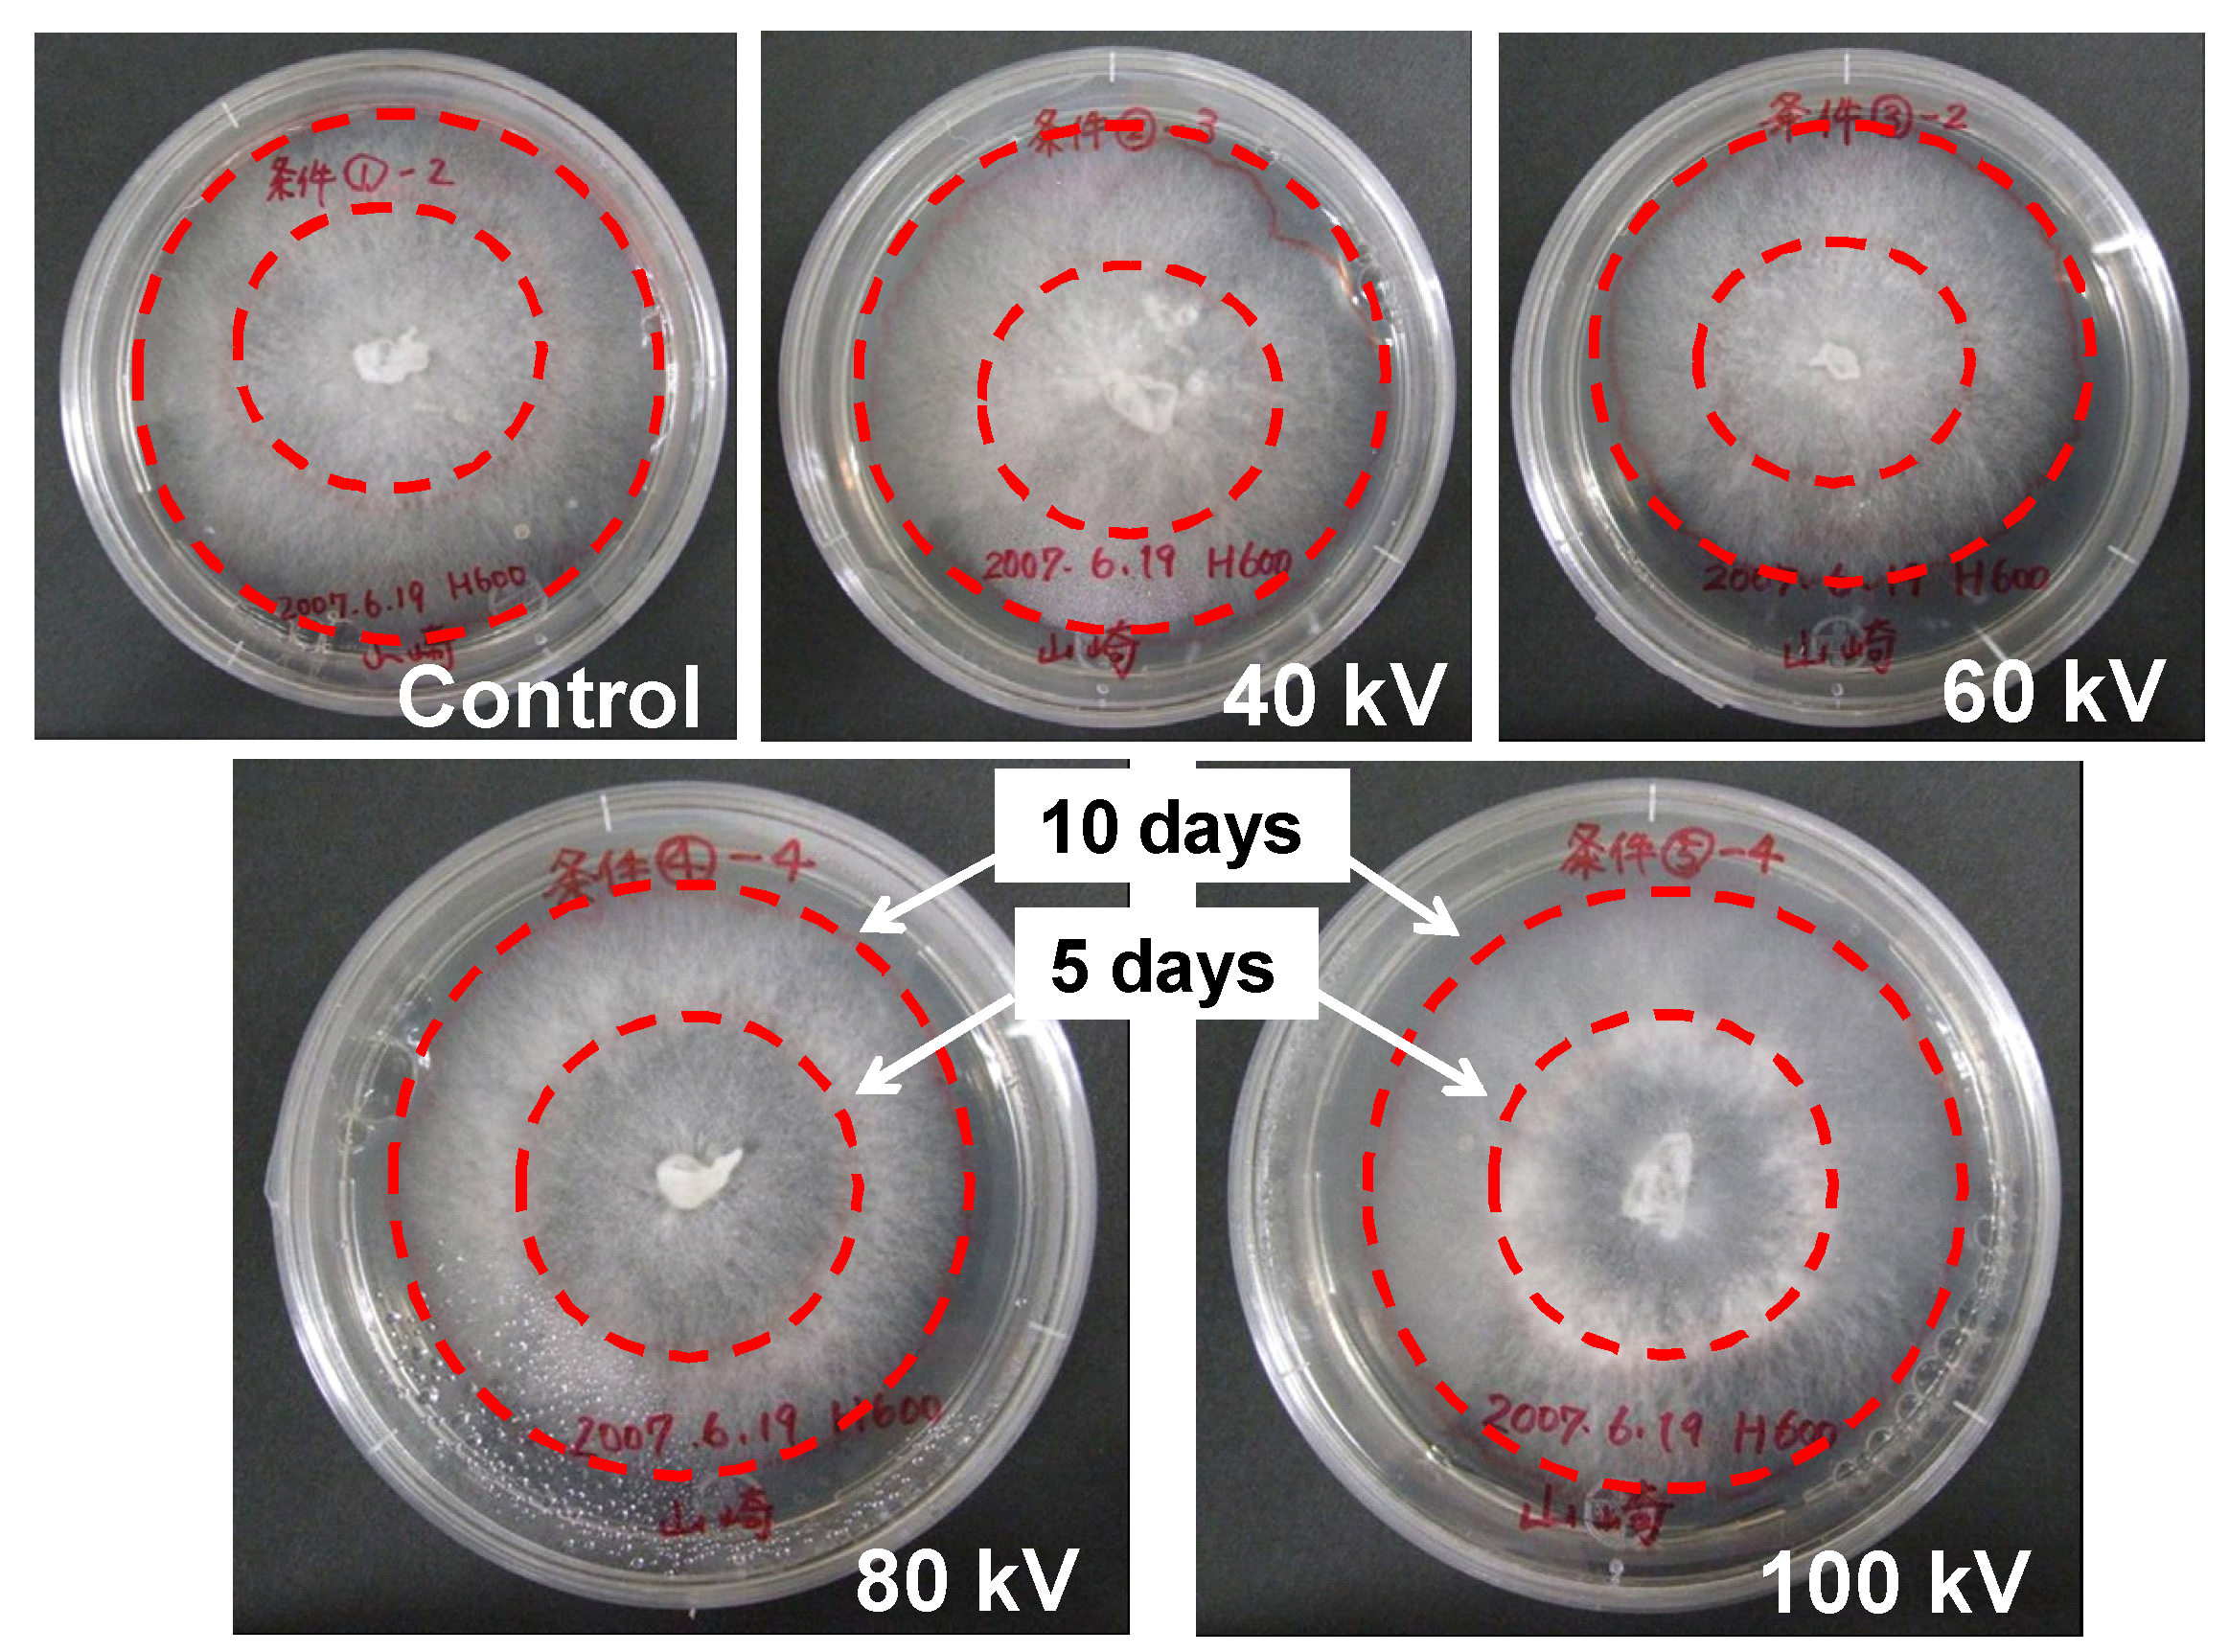

Effect of Electrical Stimulation on Fruit Body Formation in Cultivating Mushrooms
Abstract
:1. Introduction
2. Materials and Methods
2.1. Strains
2.2. Culture Media and Growth Conditions


2.3. Electrical Stimulation
2.4. Fruiting Body Yield
3. Results
3.1. Electrical Characteristics of the Cultivation Bed


3.2. Fruiting Body Yield in Log Cultivation
3.2.1. Yield of L. edodes


3.2.2. Time-History of L. edodes Yield


3.2.3. Yield of P. nameko and N. sublateritium


3.3. Fruiting Body Yield in Sawdust Substrate Cultivation


4. Discussion

5. Conclusions
Acknowledgments
Conflicts of Interest
References
- Murr, L.E. Plant growth response in an electrokinetic field. Nature 1969, 207, 1177–1178. [Google Scholar]
- McKee, G.W.; Knievel, D.P.; Poznaniak, D.T.; Bankoske, J.W. Effect of 60-Hz high intensity electric fields on living plants. IEEE Trans. Power Appar. Syst. 1978, PAS-97, 1177–1181. [Google Scholar] [CrossRef]
- Takaki, K.; Takahata, J.; Watanabe, S.; Satta, N.; Yamada, O.; Fujio, T.; Sasaki, Y. Improvements in plant growth rate using underwater discharge. J. Phys. Conf. Ser. 2013, 418, 012140:1– 012140:7. [Google Scholar]
- Eing, C.; Bonnet, S.; Pacher, M.; Puchta, M.; Frey, W. Effects of nanosecond pulsed electric field exposure on arabidopsis thaliana. IEEE Trans. Dielectr. Electr. Insul. 2009, 16, 1322–1328. [Google Scholar]
- Jitsufuchi, Y.; Yamamoto, M. Research for Improvement of Lentinula edodes Cultivation: Application of Electric Stimulation for Mushroom Cultivation; (in Japanese). Kyushu Electrical Co.: Fukuoka, Japan, 1987. [Google Scholar]
- Tsukamoto, S.; Maeda, T.; Ikeda, M.; Akiyama, H. Application of pulsed power to mushroom culturing. In Proceedings of the 14th IEEE International Pulsed Power Conference, Dallas, TX, USA, 15–18 June 2003; Volume 2, pp. 1116–1119.
- Takaki, K.; Yamazaki, N.; Mukaigawa, S.; Fujiwara, T.; Kofujita, H.; Takahashi, K.; Narimatsu, M.; Nagane, K. Fruit body formation of basidiomycete by pulse voltage stimulations. Front. Appl. Plasma Technol. 2009, 2, 61–64. [Google Scholar]
- Kudo, S.; Mitobe, S.; Yoshimura, Y. Electric stimulation multiplication of Lentinulus edodes. J. Inst. Electrost. Jpn. 1999, 23, 186–190. [Google Scholar]
- Ohga, S.; Iida, S.; Koo, C.-D.; Cho, N.-S. Effect of electric impulse on fruit body production on Lentinula edodes in the sawdust-based substrate. Mushroom Sci. Biotechnol. 2001, 9, 7–12. [Google Scholar]
- Ohga, S.; Cho, N.S.; Li, Y.; Royse, D.J. Utilization of pulsed power to stimulate fructification of edible mushroom. Mushroom Sci. 2004, 16, 343–352. [Google Scholar]
- Takaki, K.; Kanesawa, K.; Yamazaki, N.; Mukaigawa, S.; Fujiwara, T.; Takahasi, K.; Yamasita, K.; Nagane, K. Effect of pulsed high-voltage stimulation on Pholiota nameko mushroom yield. Acta Phys. Pol. A 2009, 115, 953–956. [Google Scholar]
- Takaki, K.; Kanesawa, K.; Yamazaki, N.; Mukaigawa, S.; Fujiwara, T.; Takahasi, K.; Yamasita, K.; Nagane, K. Improvement of edible mushroom yield by electric stimulations. J. Plasma Fusion Res. Ser. 2009, 8, 556–559. [Google Scholar]
- Ohga, S.; Iida, S. Effect of Electric Impulse on sporocarp formation of ectomycorrhizal fungus Laccaria laccata in Japanese red pine plantation. J. For. Res. 2001, 6, 37–41. [Google Scholar] [CrossRef]
- Islam, F.; Ohga, S. The response of fruit body formation on Tricholoma matsutake in situ condition by applying electric pulse stimulator. ISRN Agron. 2012, 2012, 462724:1–462724:6. [Google Scholar]
- Takaki, K.; Kanesawa, K.; Mukaigawa, S.; Fujiwara, T.; Go, T. Energy efficiency of corona discharge reactor driven by inductive energy storage system pulsed power generator. IEEE Trans. Dielectr. Electr. Insul. 2007, 14, 834–845. [Google Scholar] [CrossRef]
- Bluhm, H. Pulsed Power Systems; Springer: Berlin, Germany, 2006; pp. 73–76. [Google Scholar]
- Takahashi, K.; Sasaki, Y.; Mukaigawa, S.; Takaki, K.; Fujiwara, T.; Satta, N. Purification of high-conductivity water using gas-liquid phase discharge reactor. IEEE Trans. Plasma Sci. 2010, 38, 2694–2700. [Google Scholar] [CrossRef]
- Ng, W.L.; Ng, T.P.; Kwan, H.S. Cloning and characterization of two hydrophobin genes differentially expressed during fruit body development in Lentinula edodes. FEMS Microbiol. Lett. 2000, 185, 139–145. [Google Scholar] [CrossRef]
- Jackson, J.D. Classical Electrodynamics; Wiley: Hoboken, NJ, USA, 1998; p. 220. [Google Scholar]
- Tsukamoto, S.; Kudoh, H.; Ohga, S.; Yamamoto, K.; Akiyama, H. Development of an automatic electrical stimulator for mushroom sawdust bottle. In Proceedings of the 15th IEEE International Pulsed Power Conference, Monterey, CA, USA, 13–17 June 2005; pp. 1437–1440.
- Wessels, J.G.H. Gene expression during fruiting in Schizophyllum commune. Mycol. Res. 1992, 96, 609–620. [Google Scholar] [CrossRef]
- Buescher, E.S.; Schoenbach, K.H. Effects of submicrosecond, high intensity pulsed electric fields on living cells—Intracellular electromanipulation. IEEE Trans. Dielectr. Electr. Insul. 2003, 10, 788–794. [Google Scholar] [CrossRef]
- Katsuki, S.; Nomura, N.; Koga, H.; Akiyama, H.; Uchida, I.; Abe, S.-I. Biological effects of narrow band pulsed electric fields. IEEE Trans. Dielectr. Electr. Insul. 2007, 14, 663–668. [Google Scholar]
- Mattar, J.; Turk, M.; Nonus, M.; Lebovka, N.I.; Zakhem, H.El.; Vorobiev, E. Electro-stimulation of S. cerevisiae wine yeasts by pulsed electric field and its effects on fermentation capacity. J. Biol. Phys. 2013, 1034, 1304.5681:1–1304.5681:12. [Google Scholar]
- Mushroom stimulation high-voltage generator “Raizo”. Available online: http://www.greentechno.co.jp/power/kinoko.html (accessed on 18 January 2014).
- Shiitake mushroom price in Shiitake Brothers Co. Available online: http://www.shiitakebrothers.com/sale/sale.html (accessed on 18 January 2014).
© 2014 by the authors; licensee MDPI, Basel, Switzerland. This article is an open access article distributed under the terms and conditions of the Creative Commons Attribution license (http://creativecommons.org/licenses/by/3.0/).
Share and Cite
Takaki, K.; Yoshida, K.; Saito, T.; Kusaka, T.; Yamaguchi, R.; Takahashi, K.; Sakamoto, Y. Effect of Electrical Stimulation on Fruit Body Formation in Cultivating Mushrooms. Microorganisms 2014, 2, 58-72. https://doi.org/10.3390/microorganisms2010058
Takaki K, Yoshida K, Saito T, Kusaka T, Yamaguchi R, Takahashi K, Sakamoto Y. Effect of Electrical Stimulation on Fruit Body Formation in Cultivating Mushrooms. Microorganisms. 2014; 2(1):58-72. https://doi.org/10.3390/microorganisms2010058
Chicago/Turabian StyleTakaki, Koichi, Kohei Yoshida, Tatsuya Saito, Tomohiro Kusaka, Ryo Yamaguchi, Kyusuke Takahashi, and Yuichi Sakamoto. 2014. "Effect of Electrical Stimulation on Fruit Body Formation in Cultivating Mushrooms" Microorganisms 2, no. 1: 58-72. https://doi.org/10.3390/microorganisms2010058
APA StyleTakaki, K., Yoshida, K., Saito, T., Kusaka, T., Yamaguchi, R., Takahashi, K., & Sakamoto, Y. (2014). Effect of Electrical Stimulation on Fruit Body Formation in Cultivating Mushrooms. Microorganisms, 2(1), 58-72. https://doi.org/10.3390/microorganisms2010058
